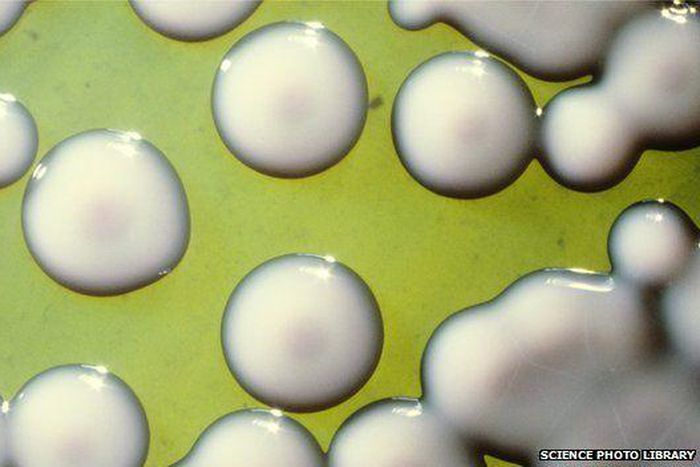
___3744990___https:______static.pulse.com.gh___webservice___escenic___binary___3744990___2015___5___11___17____82916216_m8740594-cultured_typhoid_bacteria-spl

Drug-resistant form of disease spreading across Africa, Asia - Experts warn
)
Experts have warned that an antibiotic-resistant form of typhoid is spreading across Africa and Asia, posing a major health threat.
BBC reports that researchers from the Wellcome Trust, who have been tracking the hard-to-treat infection, analysed bacterial samples from 63 countries and said nearly half were resistant to standard antibiotic treatments.
Out of the 63 countries the researchers looked at, 21 had H58.
They added that this form of typhoid; a multidrug-resistant strain of typhoid called H58 was replacing regular typhoid in many countries, adding that over-reliance on these drugs was to blame.
They urged that doctors now need to use other, more expensive and less readily available antibiotics to treat typhoid fever.
According to Dr Kathryn Holt, from the University of Melbourne and one of the study authors, H58 was gaining a firm foothold.
In her words,
"Multidrug-resistant typhoid has been coming and going since the 1970s and is caused by the bacteria picking up novel antimicrobial resistance genes, which are usually lost when we switch to a new drug. In H58, these genes are becoming a stable part of the genome, which means multiple-antibiotic resistant typhoid is here to stay."
Typhoid is caused by the highly contagious bacterium Salmonella typhi, spread from person to person by food and water that is contaminated with traces of infected faeces or urine, which can be cut by improved water, sanitation and hygiene.
Vaccines against typhoid also exist, but they are not available in all parts of the world, nor are they 100% protective.

)
)

)
)
)
)
)
)
)
,fit(112:112))